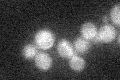
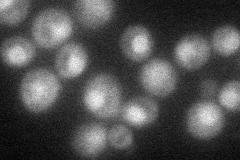
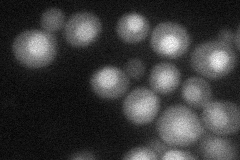
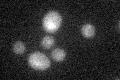

View description
Mitochondrial inner membrane protein that binds to the 5' UTR of the COX3 mRNA to activate its translation together with Pet122p and Pet494p; also binds to the COX1 Group I intron AI5 beta to facilitate exon ligation during splicing
Localization:
Intensity:
Fold change:
Significance:
-
C’ GFP library in SD
below threshold16.76 -
N' NOP1pr-GFP in SD
cytosol,nucleus46.8483 -
N' TEF2pr-mCherry in SD
nucleus36.6563 -
N' NATIVEpr-GFP in SD

missing0 -
N' TEF2pr-VC and Cyto-VN in SD

#N/A0 -
C’ GFP library in SD+DTT
cytosol16.180.96No -
C’ GFP library in SD+H2O2

cytosol17.771.05No -
C’ GFP library in Starvation Media

cytosol17.91.06No -
C’ GFP library on the background of Pup2-DaMP

N/A -
C’ GFP library on the background of CCT mutant

N/A0N/AYes
